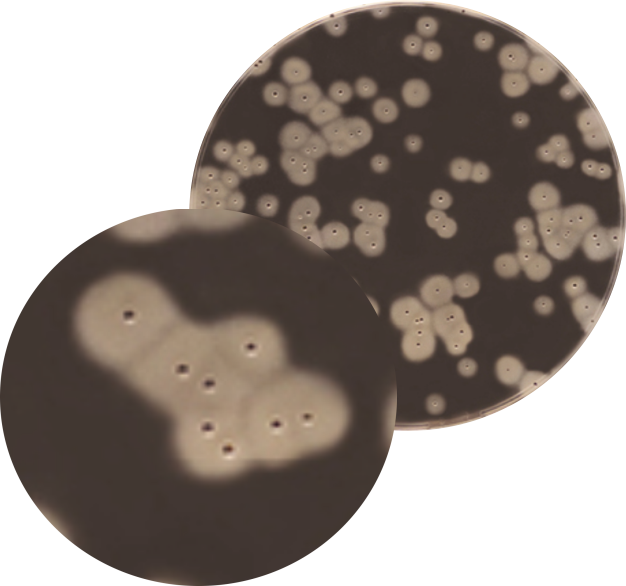

EASY STAPH® Agar
Kromojenik (Chromogenic) Staphylococcus Agar
Gıda ürünlerinde, hayvan yemlerinde ve çevresel örneklerde koagülaz pozitif Staphylococci türlerinin sayımı için alternatif ve valide bir yöntemdir.
Performans
- S.hyicus ve S.intermedius'un enterotoksijenik suşları da dahil bütün koagülaz pozitif Staphylococcus'ların tespitini ve sayımını sağlar.
Kolay - Hızlı - Ekonomik
- Renkli ve susuz ürünler de dahil tüm gıda türleri için sınırsız kullanımlı tek protokol ile kolay ve ekonomiktir.
- Koagülaz pozitif Staphylococcus türlerinin 22 saat içinde tespiti ve sayımı ile hızlıdır.
- Doğrulama gerekmeksizin hale ile çevrili kolonilerin sayımı ile kolay ve ekonomiktir.
Seçici
- Enterotoksijenik türler de dahil koagülaz pozitif Staphylococcus türlerinin seçici tespitini sağlar.
- Sekonder floraya optimal inhibisyon uygular.
- Eşsiz bileşimi ile koagülaz pozitif Staphylococcus türlerin fibrin opak bir hale ile çevrili beyaz, gri ya da siyah koloniler oluşturmasını sağlar.
Güvenilir
- ISO 6888-2 standardı referans alınarak ISO 16140 alternatif metot validasyon standardı kapsamında AFNOR tarafından BKR 23/10 - 12/15 referans numarası ile valide edilmiştir.
- Dökme plak ve yüzey ekim yöntemlerinin her ikisi için de valide edilmiştir.